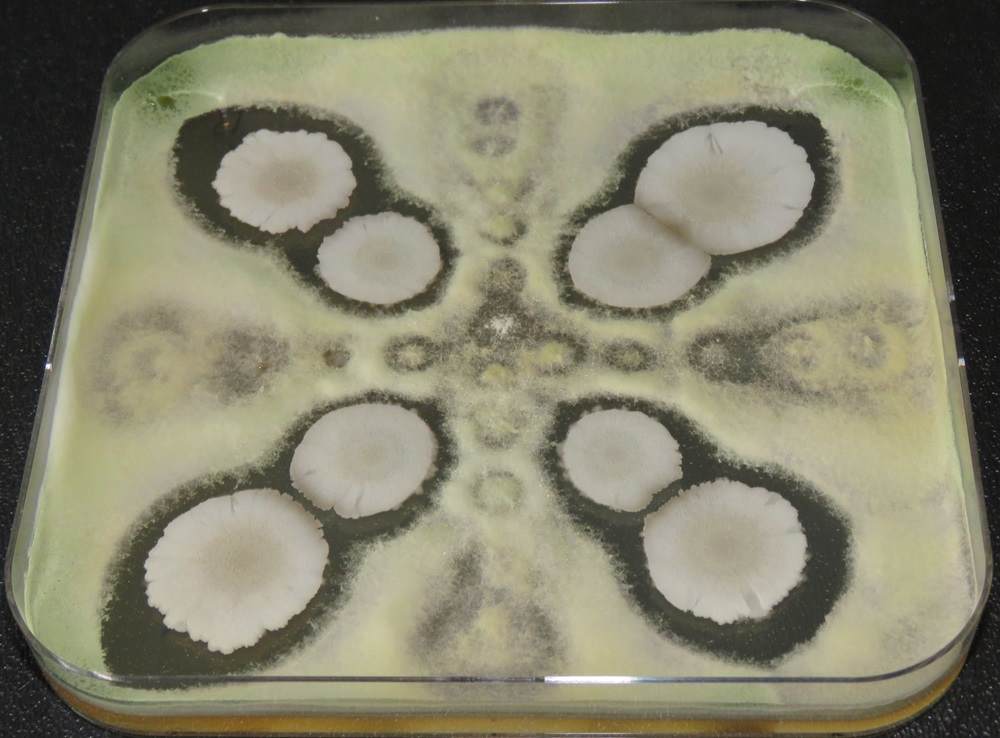
A bacillus and trichoderma growing on the same agar plate

Les défis de l'application de micro-organismes sur les semences
La grande diversité des micro-organismes fait que toutes ces méthodes d'enrobage des semences présentent leurs propres défis pour l’apllication de micro-organismes.
Pelliculage : il s'agit d'une formulation complexe utilisée pour réduire l'émission de poussières par les semences traitées et pour obtenir une surface de semence lisse. Avec une couche de film de seulement quelques micromètres d'épaisseur, il ne modifie pas la forme de la graine.
Enrobage : création d’une enveloppe entourant la graine qui augmente à la fois la taille et le poids de la graine, lui donnant une forme lisse et uniforme ; il s'agit généralement d'une sphère ou d'un ovoïde.
Incrustation : comme un enrobage, mais avec une coque plus fine, ce qui permet à la graine incrustée de conserver une plus grande partie de sa forme originale.
Les micro-organismes sont vivants, ce qui les rend vulnérables à l'environnement. Ils ont développé toutes sortes de mécanismes de survie. Aucun microbe ne réagit de la même manière.
Il n'existe pas un microbe mais des microbes
Les micro-organismes couvrent un large éventail de familles. Dans le cas présent, nous nous intéressons plus particulièrement aux bactéries et aux champignons. Il existe un nombre incalculable de bactéries et de champignons différents, différents par leur famille, leur structure de survie, leur taille et bien d'autres aspects. Toutes ces caractéristiques doivent être prises en compte lors de l'élaboration d'un enrobage de semences compatible. Nous allons nous pencher un peu plus en profondeur sur certaines des considérations importantes.La taille compte
Lorsque l'on examine certains micro-organismes bien connus dans l'industrie, on observe une nette différence de taille : Bacillus spp. 1-2 µm, Trichoderma spp. 2-5 µm, champignons mycorhiziens 50-500 µm. Une couche de pelliculant sur une graine ne fait que quelques µm d'épaisseur, ce qui signifie qu'une spore de Mycorhize dépassera de la couche et ne restera pas collée à la graine. Pour un microbe dont la taille des spores est plus importante, il est conseillé d'utiliser l’incrustation ou l’enrobage, afin d'incorporer complètement la spore dans l’amalgame.

Un milieu hostile ou un cocon douillet
Lorsque des microbes sont appliqués aux semences, ils peuvent être confrontés à de nombreux problèmes de compatibilité. Non seulement avec les matériaux d'enrobage, mais aussi avec les autres composés appliqués aux semences, par exemple lorsqu'un fongicide est combiné à un champignon.
Comme mentionné ci-dessus, un film coat (pelliculant) est une formulation complexe qui peut contenir 15 composés différents. Tous ces composants peuvent avoir un impact sur la viabilité du microbe. Parfois, les composés individuels sont compatibles, mais lorsqu'ils sont combinés, des interactions ou des cumuls (effet de seuil) font que le mélange n'est plus compatible. Pour rendre les choses encore plus complexes : l'expérience nous a appris que les microbes d'un même genre, voire d'une même espèce, peuvent réagir différemment aux composés et aux formulations. Par exemple, nous avons testé un même pelliculant avec trois souches différentes de Trichoderma (voir le graphique ci-dessous). La viabilité du premier Trichoderma est restée stable pendant 24 heures. La viabilité du troisième Trichoderma a diminué de manière significative dans les 24 heures et celle du deuxième Trichoderma était même inférieure à la limite de détection après 24 heures.

D’autres composés peuvent être appliqués aux semences avec les micro-organismes comme les nutriments, les biostimulants et les produits chimiques de protection des plantes, (les fongicides, les insecticides, les répulsifs, ...). L'application d'un champignon en même temps qu'un fongicide chimique peut entraîner des problèmes de compatibilité, qui peuvent être résolus par l'utilisation d'un enrobage. Comme il s'agit d'une couche épaisse, les différents composés peuvent être physiquement séparés.
Interactions microbe - microbe
La combinaison de plusieurs micro-organismes ayant des effets bénéfiques différents peut apporter une meilleure protection aux plantes. Mais tous les microbes bénéfiques ne peuvent pas être combinés sans conséquences. Sur la photo, un Bacillus et un Trichoderma sont cultivés sur la même plaque de gélose. Les zones d'inhibition entre le Bacillus et le Trichoderma indiquent que l'un ou les deux microbes excrètent des composés pour maintenir l'autre microbe à distance. Il existe également de nombreuses combinaisons de Bacillus et de Trichoderma qui sont très compatibles, mais cela montre qu'il ne faut jamais rien supposer. Il faut avant tout tester.